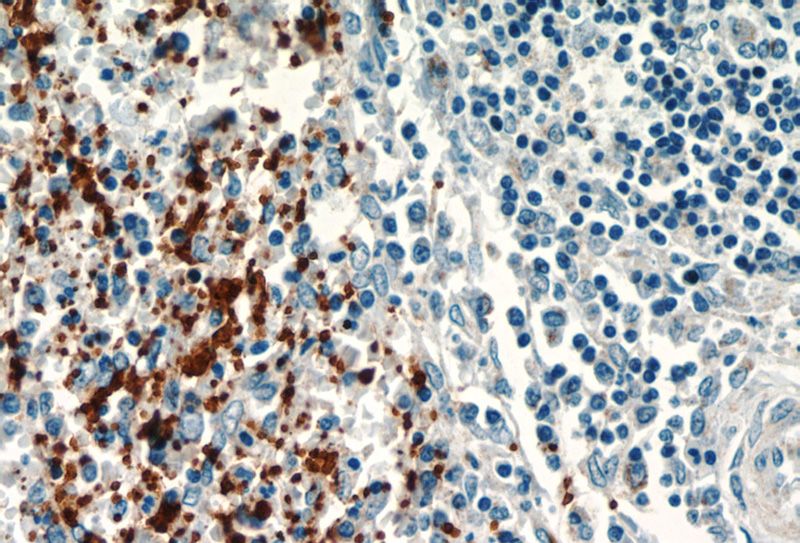
Immunohistochemistry of paraffin-embedded human spleen slide using Catalog No:109121(ITGA2B Antibody) at dilution of 1:50

-
Product Name
CD41/Integrin alpha 2b antibody
- Documents
-
Description
CD41/Integrin alpha 2b Rabbit Polyclonal antibody. Positive WB detected in human blood tissue. Positive IP detected in human plasma tissue. Positive IHC detected in human spleen tissue. Observed molecular weight by Western-blot: 125 kDa
-
Tested applications
ELISA, IHC, IP, WB
-
Species reactivity
Human; other species not tested.
-
Alternative names
CD41 antibody; CD41B antibody; GP2B antibody; GPalpha IIb antibody; GPIIb antibody; GTA antibody; HPA3 antibody; Integrin alpha IIb antibody; ITGA2B antibody; ITGAB antibody
- Immunogen
-
Isotype
Rabbit IgG
-
Preparation
This antibody was obtained by immunization of CD41/Integrin alpha 2b recombinant protein (Accession Number: NM_000419). Purification method: Antigen affinity purified.
-
Clonality
Polyclonal
-
Formulation
PBS with 0.1% sodium azide and 50% glycerol pH 7.3.
-
Storage instructions
Store at -20℃. DO NOT ALIQUOT
-
Applications
Recommended Dilution:
WB: 1:1000-1:10000
IP: 1:1000-1:10000
IHC: 1:20-1:200
-
Validations

human blood tissue were subjected to SDS PAGE followed by western blot with Catalog No:109121(ITGA2B Antibody) at dilution of 1:3000

Immunohistochemistry of paraffin-embedded human spleen slide using Catalog No:109121(ITGA2B Antibody) at dilution of 1:50
Immunohistochemistry of paraffin-embedded human spleen slide using Catalog No:109121(ITGA2B Antibody) at dilution of 1:50

IP Result of anti-CD41/Integrin alpha 2b (IP:Catalog No:109121, 4ug; Detection:Catalog No:109121 1:2000) with human plasma tissue lysate 4000ug.
-
Background
The integrins are a superfamily of cell adhesion receptors that bind to extracellular matrix ligands, cell-surface ligands, and soluble ligands (PMID: 17543136). They are transmembrane αβ heterodimers and at least 24 distinct integrin heterodimers are formed by the combination of 18 α and eight β known subunits (PMID: 17543136; 20029421). In addition to mediating cell adhesion, integrins also play important roles in modulating signal transduction pathways that control cellular responses including migration, proliferation, differentiation, and apoptosis (PMID:19118207). Integrin alpha-IIb (ITGA2B, CD41) is expressed on platelets, megakaryocytes and some hematopoietic progenitor cells (PMID: 11934866). This protein undergoes post-translational cleavage to yield disulfide linked light and heavy chains which join with integrin beta3 (CD61) to form a receptor for fibronectin, fibrinogen, plasminogen, prothrombin, thrombospondin and vitronectin. Integrin alpha-IIb/beta-3 is crucial for platelet aggregation through binding of soluble fibrinogen.
Related Products / Services
Please note: All products are "FOR RESEARCH USE ONLY AND ARE NOT INTENDED FOR DIAGNOSTIC OR THERAPEUTIC USE"
